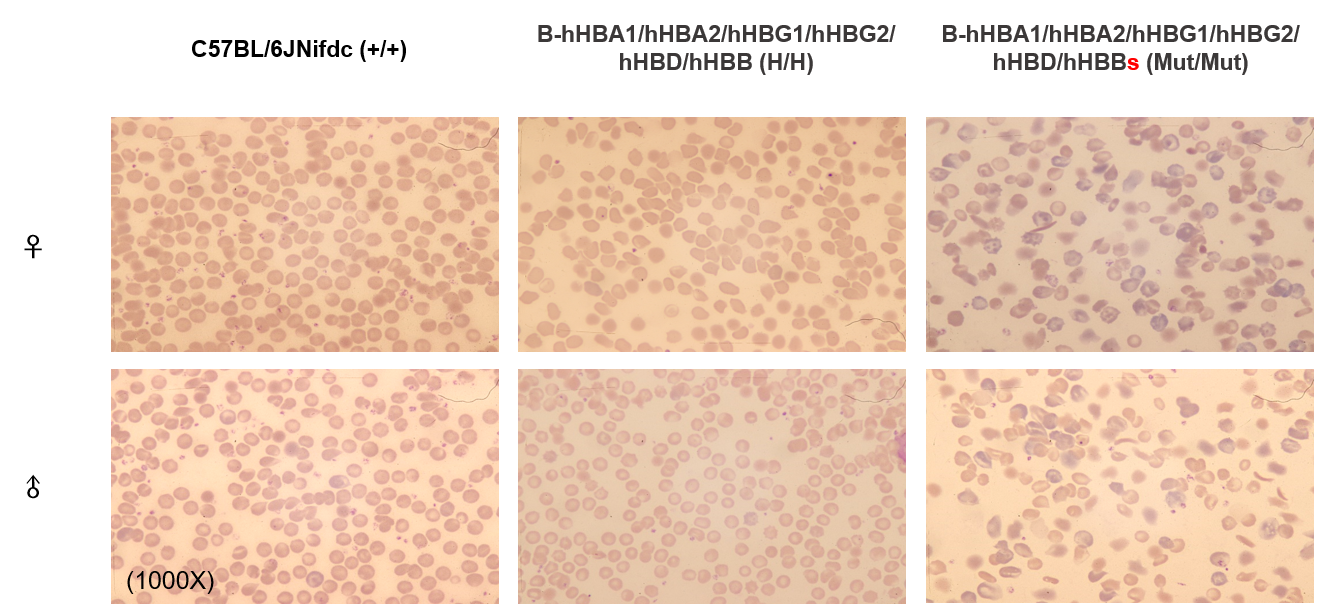

B6; 129S-Hba-a1/Hba-a2tm1(HBA1/HBA2)Bcgen Hbb-bs/Hbb-bttm1(HBG1/hHBG2/hHBD/hHBB)Bcgen /Bcgen • 113687

Gene targeting strategy for B-hHBA1/hHBA2/hHBG1/hHBG2/hHBD/hHBB mice(B6; 129S).
1.The mouse's Hba-a1/Hba-a2 genes were replaced with human HBA1/HBA2 in B-hHBA1/hHBA2 mice(129S2).
2. The mouse's Hbb-bs/Hbb-bt genes were replaced with human HBG1/hHBG2/hHBD/hHBB in B-hHBG1/hHBG2/hHBD/hHBB mice.
B-hHBA1/hHBA2/hHBG1/hHBG2/hHBD/hHBB mice(B6; 129S) were obtained by mating B-hHBA1/hHBA2 mice(129S2) and B-hHBG1/hHBG2/hHBD/hHBB mice

Strain specific analysis of HBA1 and HBA2 mRNA expression in wild-type 129S mice and homozygous B-hHBA1/hHBA2 mice(129S2) by RT-PCR. Spleen RNA was isolated from wild-type 129S mice (+/+) and homozygous B-hHBA1/hHBA2(129S2) (H/H), then cDNA libraries were synthesized by reverse transcription, followed by PCR with human HBA1 and HBA2 primers. Mouse Hba mRNA was exclusively detectable in wild-type mice but not in homozygous B-hHBA1/hHBA2 mice(129S2). Human HBA1 and HBA2 mRNA were exclusively detectable in homozygous B-hHBA1/hHBA2 mice(129S2).

Strain specific analysis of HBB mRNA expression in wild-type C57BL/6JNifdc mice and heterozygous B-hHBG1/hHBG2/hHBD/hHBB mice by RT-PCR. Spleen RNA was isolated from wild-type C57BL/6JNifdc mice (+/+) and heterozygous B-hHBG1/hHBG2/hHBD/hHBB mice (H/+), then cDNA libraries were synthesized by reverse transcription, followed by PCR with human HBG1, HBG2, HBD and HBB primers. mGapdh was detected as internal control. HBG1, HBG2, HBD and HBB mRNA were exclusively detectable in heterozygous B-hHBG1/hHBG2/hHBD/hHBB mice but not in wild-type mice.

Complete blood count (CBC) of wild-type C57BL/6JNifdc mice, homozygous B-hHBA1/hHBA2/hHBG1/hHBG2/hHBD/hHBB mice(B6; 129S) and homozygous B-hHBA1/hHBA2/hHBG1/hHBG2/hHBD/hHBBs mice(B6; 129S). Values are expressed as mean ± SD.

Biochemical test of wild-type C57BL/6JNifdc mice, homozygous B-hHBA1/hHBA2/hHBG1/hHBG2/hHBD/hHBB mice(B6; 129S) and homozygous B-hHBA1/hHBA2/hHBG1/hHBG2/hHBD/hHBBs mice(B6; 129S). Values are expressed as mean ± SD.
Blood smear analysis in wild-type C57BL/6JNifdc mice, homozygous B-hHBA1/hHBA2/hHBG1/hHBG2/hHBD/hHBB mice(B6; 129S) and homozygous B-hHBA1/hHBA2/hHBG1/hHBG2/hHBD/hHBBs mice(B6; 129S). The blood smear analysis results showed that the homozygous B-hHBA1/hHBA2/hHBG1/hHBG2/hHBD/hHBB mice(B6; 129S) exhibited normal red blood cell morphology.

Spleen analysis in wild-type C57BL/6JNifdc mice, homozygous B-hHBA1/hHBA2/hHBG1/hHBG2/hHBD/hHBB mice(B6; 129S) and homozygous B-hHBA1/hHBA2/hHBG1/hHBG2/hHBD/hHBBs mice(B6; 129S). No significant differences were observed in the spleen size between homozygous B-hHBA1/hHBA2/hHBG1/hHBG2/hHBD/hHBB mice(B6; 129S) and wild-type C57BL/6JNifdc mice.